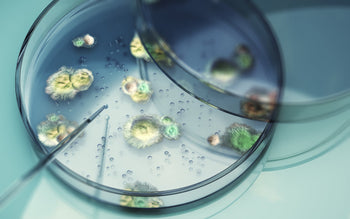

Vaginal Health Insights
Featured

Featured
Empowering Women Through Menopause: Dr. Polly Watson on Hormonal Health and Functional Medicine
Dr. Polly Watson, a board-certified OB-GYN with over 20 years of experience, is reshaping the way women approach hormonal health. Through a holistic, patient-centered approach, she empowers women to understand and manage their hormones with personalized care that extends beyond traditional prescriptions.
Recent

Interviews
Interview: Dr. Rebecca Levy-Gantt on Vaginal Health and the Power of PCR Diagnostics

Vaginal microbiome
VENUS Study and qPCR Test: Progress, Milestones and New Opportunities Ahead

Vaginal microbiome
Did You Know…that the vaginal microbiome is connected to maternal mortality in Black women?

Biomatch technology
Meeting Your Patients Needs
All Articles

Interviews
Interview: Dr. Rebecca Levy-Gantt on Vaginal Health and the Power of PCR Diagnostics
Dr. Rebecca Levy-Gantt, a Board-Certified ObGyn and certified menopause specialist, shares her insights on the importance of lactobacilli and vaginal pH, and why PCR tests are an invaluable part of her approach to vaginal diagnosis.

Vaginal microbiome
VENUS Study and qPCR Test: Progress, Milestones and New Opportunities Ahead

Featured
Empowering Women Through Menopause: Dr. Polly Watson on Hormonal Health and Functional Medicine
Dr. Polly Watson, a board-certified OB-GYN with over 20 years of experience, is reshaping the way women approach hormonal health. Through a holistic, patient-centered approach, she empowers women to understand and manage their hormones with personalized care that extends beyond traditional prescriptions.

Vaginal conditions
Beyond BV: Why the Vaginal Microbiome Is Central to STI Risk, Recurrent Infections, and Vulvar Disease
The vaginal microbiome, after so many years in the background, is now recognized as a key determinant of women’s health. For clinicians, this reframes BV as a critical point of intervention

Interviews
Redefining Pelvic Pain: Dr. Sonia Bahlani on Personalized Care and Breaking the Silence Around Vaginal Health
Dr. Sonia Bahlani is an OB/GYN and urology-trained specialist who emphasizes a personalized, holistic approach to diagnosing and treating pelvic and vaginal pain.

Vaginal microbiome
Reconsidering the Role of Male Partners in Recurrent Bacterial Vaginosis
Although not universally classified as a sexually transmitted infection, the study shows that BV may recur due to a combination of intrinsic disruptions to the vaginal microbiota and sexual transmission, with untreated male partners potentially playing a key role in its persistence.

Vaginal microbiome
Exploring Cervical Cancer Disparities in Native American Women through Vaginal Microbiome Insights

Interviews
Integrating Pelvic Floor Therapy in the Treatment of Endometriosis and Perimenopause: Enhancing Patient Care and Breaking Stigmas
This month we interview Beyond Basics, an international leader in pelvic floor physical therapy in NYC since 2003, on their approach to endometriosis and perimenopause.

Vaginal microbiome
Microbes and Love: How Your Microbiome Influences Attraction and Intimacy
While we often think of attraction as a mix of chemistry, personality, and looks, current research suggests that our microbiome may play a hidden role in who we’re drawn to and how we experience intimacy.

Featured
Empowering Women Through Menopause: Dr. Polly Watson on Hormonal Health and Functional Medicine
Dr. Polly Watson, a board-certified OB-GYN with over 20 years of experience, is reshaping the way women approach hormonal health. Through a holistic, patient-centered approach, she empowers women to understand and manage their hormones with personalized care that extends beyond traditional prescriptions.
Featured
Beyond BV: Why the Vaginal Microbiome Is Central to STI Risk, Recurrent Infections, and Vulvar Disease
The vaginal microbiome, after so many years in the background, is now recognized as a key determinant of women’s health. For clinicians, this reframes BV as a critical point of intervention

Featured
Redefining Pelvic Pain: Dr. Sonia Bahlani on Personalized Care and Breaking the Silence Around Vaginal Health
Dr. Sonia Bahlani is an OB/GYN and urology-trained specialist who emphasizes a personalized, holistic approach to diagnosing and treating pelvic and vaginal pain.